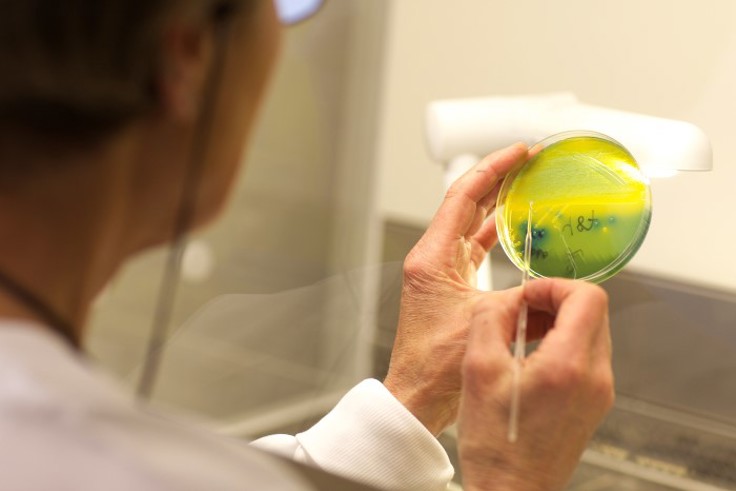

Funn av E. coli i mat og vann - hva betyr det?
Artikkel
|Oppdatert
Funn av E. coli betyr som regel at produktet det er funnet i, enten det gjelder en matvare eller vann, nylig har blitt forurenset med avføring. Funnet er dermed et uttrykk for dårlig hygiene, og er et tegn på at det også kan finnes sykdomsfremkallende bakterier der.
De aller fleste E. coli bakterier er vanligvis ufarlige og forårsaker ikke sykdom så lenge de oppholder seg i tarmen. Det finnes imidlertid noen grupper av E. coli som kan gi tarminfeksjoner hos mennesker. De fire vanligste gruppene av sykdomsfremkallende E.coli-bakterier heter EHEC, EIEC, EPEC og ETEC. Den mest alvorlige varianten er EHEC.
EHEC-bakterien kan gi diaré, som av og til er blodig. Den kan vare i 4–10 dager hos voksne og noe lenger hos barn. Noen former av EHEC-bakterien kan i sjeldne tilfeller gi alvorlige komplikasjoner i form av den alvorlige nyresykdommen hemolytisk-uremisk syndrom (HUS), spesielt hos barn og eldre.
Andre typer av EHEC-bakterien kan gi mildere sykdomsbilde.
Forebygging av sykdom
Gjennomsteking og gjennomkoking av mat er viktige forebyggende råd. Varmebehandling forebygger de fleste infeksjoner som kan smitte gjennom mat og vann, både fra bakterier, virus og parasitter.
Vær bevisst på hvor maten kommer fra, om maten fra produsentens side er ment å spises rå eller varmebehandlet, og hvordan maten bør tilberedes, se forebyggende råd for å redusere risiko for smitte fra mat og vann.
Rådene for god kjøkkenhygiene finnes på en plakat som kan skrives ut og henges opp både hjemme og på jobb.